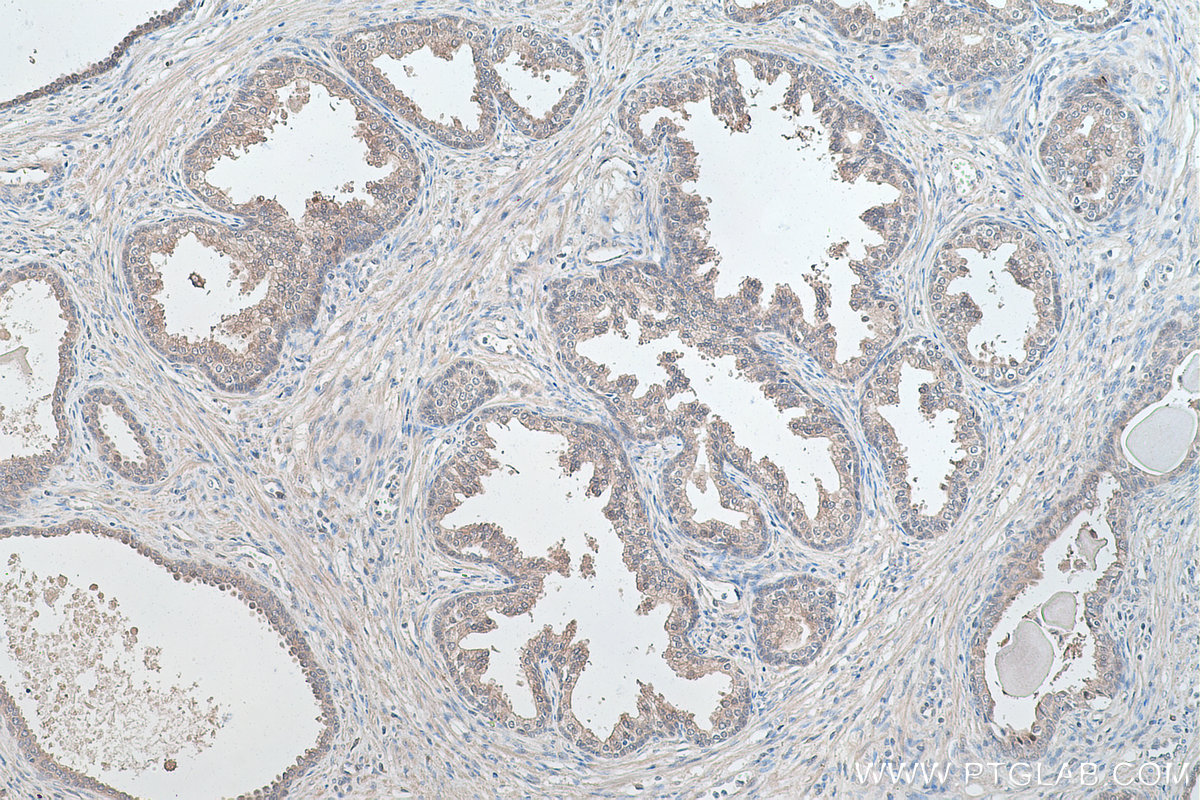

IHCeasy® FKBP4/FKBP52 Ready-To-Use IHC Kit
FKBP4/FKBP52 Ready-to-use reagent kit for IHC.
Reactivity
Human
Sample Type
FFPE tissue
Cat no : KHC0417
Synonyms
51 kDa FK506 binding protein, 52 kDa FK506 binding protein, 52 kDa FKBP, 59 kDa immunophilin, FK506 binding protein 4, FK506 binding protein 4, 59kDa, FKBP 4, FKBP 52, FKBP4, FKBP51, FKBP52, FKBP59, HBI, HSP binding immunophilin, Hsp56, Immunophilin FKBP52, p52, p59, PPIase, PPIase FKBP4, Rotamase
Validation Data Gallery
Product Information
KHC0417 is a ready-to-use IHC kit for staining of FKBP4/FKBP52. The kit provides all reagents, from antigen retrieval to cover slip mounting, that require little to no diluting or handling prior to use. Simply apply the reagents to your sample slide according to the protocol and you're steps away from obtaining high-quality IHC data.
| Product name | IHCeasy FKBP4/FKBP52 Ready-To-Use IHC Kit |
| Sample type | FFPE tissue |
| Assay type | Immunohistochemistry |
| Primary antibody type | Mouse Monoclonal |
| Secondary antibody type | Polymer-HRP-Goat anti-Mouse |
| Reactivity | Human |
Kit components
| Component | Size | Concentration |
|---|---|---|
| Antigen Retrieval Buffer | 100 mL | 50× |
| Washing Buffer | 100 mL ×2 | 20× |
| Blocking Buffer | 5 mL | RTU |
| Primary Antibody | 5 mL | RTU |
| Secondary Antibody | 5 mL | RTU |
| Chromogen Component A | 0.2 mL | RTU |
| Chromogen Component B | 4 mL | RTU |
| Signal Enhancer | 5 mL | RTU |
| Counter Staining Reagent | 5 mL | RTU |
| Mounting Media | 5 mL | RTU |
| Datasheet | 1 Copy | |
| Manual | 1 Copy |
Background Information
FKBP52 (FK506 binding protein 4) is a member of the immunophilin protein family that comprises intracellular protein effectors of immunosuppressive drugs, and it is known as a steroid receptor-associated protein. As a novel regulator of microtubule dynamics, FKBP52 is associated with the motor protein dynein and with the cytoskeleton during mitosis. FKBP52 is highly expressed in CNS regions susceptible to Alzheimer's, and plays a role in modulating toxicity of Abeta peptides. The protein can associate with the Tau function, and may help to decipher and modulate the events involved in Tau-induced neurodegeneration. In addition, FKBP52 is likely to play a role in growth and development of the male genitalia.
Properties
| Storage Instructions | All the reagents are stored at 2-8°C. The kit is stable for 6 months from the date of receipt. |
| Synonyms | 51 kDa FK506 binding protein, 52 kDa FK506 binding protein, 52 kDa FKBP, 59 kDa immunophilin, FK506 binding protein 4, FK506 binding protein 4, 59kDa, FKBP 4, FKBP 52, FKBP4, FKBP51, FKBP52, FKBP59, HBI, HSP binding immunophilin, Hsp56, Immunophilin FKBP52, p52, p59, PPIase, PPIase FKBP4, Rotamase |